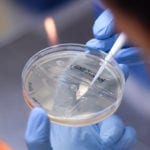

El presidente de Argentina, Alberto Fernández, llamó este martes en la ONU a construir «una vacuna contra la injusticia social» y a buscar alternativas que faciliten la «reestructuración ordenada» de las deudas de los países, para evitar así la «ola de atraso y subdesarrollo» que provoca el «endeudamiento tóxico e irresponsable».
En su debut en la Asamblea General de las Naciones Unidas, el jefe de Estado, que llegó al poder en diciembre pasado tras los cuatro años de mandato del conservador Mauricio Macri, lanzó, inspirado en la «prédica» y el «ejemplo» de su compatriota el papa Francisco, un «llamamiento» al mundo entero a recrear un multilateralismo basado en la «solidaridad».
«Esta pandemia nos ha revelado frágiles y ha recreado la necesidad de construir puentes entre personas, entre naciones y entre regiones», remarcó Fernández.
En ese sentido, consideró que si se están uniendo esfuerzos de todo el planeta para «descubrir una vacuna» contra la COVID-19, se sea capaz de «soñar y construir una vacuna contra la injusticia social, la depredación ambiental, la discriminación en todas sus formas».
«Este espíritu solidario es el que mi Gobierno ha priorizado desde su llegada, porque de la pandemia, al igual que de la pobreza, ‘nadie se salva solo'», destacó.
ALTERNATIVAS QUE ORDENEN LAS DEUDAS
En el «tormentoso contexto global» que deja el coronavirus, el presidente de Argentina -que arrastra dos años y medio de recesión e históricamente ha enfrentado problemas por su alta deuda pública- remarcó que el «endeudamiento externo tóxico e irresponsable con fines especulativos constituye otra ola de atraso y subdesarrollo».
«Instamos a la comunidad internacional a continuar buscando nuevas alternativas multilaterales que faciliten la reestructuración ordenada de las deudas y asegurar la mayor disponibilidad de recursos para la aplicación de políticas públicas para enfrentar la pandemia y sostener el crecimiento inclusivo», señaló.
Para Fernández, cuyo Gobierno acaba de cerrar, tras largas negociaciones, un acuerdo con sus acreedores para reestructurar unos 107.000 millones de dólares de bonos soberanos, «ningún país puede pagar su deuda a costa de que su pueblo quede sin salud, sin educación, sin seguridad o sin capacidad de crecer».
«Argentina logró sellar un importante acuerdo con casi la totalidad de sus acreedores externos privados, convirtiéndose en uno de los primeros países en enfrentar el desafío de afrontar una reestructuración de deuda en el marco de la pandemia», valoró el mandatario, que destacó el apoyo obtenido de parte de la comunidad internacional.
Pendientes quedan las negociaciones con el Fondo Monetario Internacional para refinanciar deuda por unos 44.000 millones de dólares, que el jefe de Estado adelantó que «se encararán de la misma manera, de forma responsable, siendo respetuosos de los compromisos contraídos, evitando al mismo tiempo poner en riesgo las condiciones que permitan la reactivación económica y la construcción de un sendero de desarrollo inclusivo y sostenible».
NUEVAS PRIORIDADES PARA EL SISTEMA MULTILATERAL
Con el convencimiento de que hay que empezar por los últimos para «llegar a todos», Fernández propuso restablecer las «prioridades» del sistema multilateral.
«Necesitamos unas Naciones Unidas 4.0, con sus valores fundacionales intactos y con la lucidez para incorporar los inmensos cambios tecnológicos en marcha, para hacerlos más humanos, más democráticos y más inclusivos socialmente», subrayó.
También pidió promover políticas económicas, industriales y sociales orientadas al cambio estructural de las economías y vio necesario «un compromiso colectivo para lograr la pronta y efectiva» implementación del Acuerdo de París contra el cambio climático.
«Nadie se salva solo en un planeta que se incendia, se inunda o se envenena», agregó.
RECLAMO POR MALVINAS Y LA AMIA
En su discurso, Fernández expuso la «desigualdad de género» que ha puesto de manifiesto la pandemia, alertó de que «el mundo pospandemia puede exacerbar la grave crisis de refugiados y desplazados» y alegó que «la respuesta debe ser la promoción y garantía de los derechos humanos de los migrantes».
Reiteró así la llamada a la solidaridad y a no quedar pasivos frente a «sanciones» que suponen los bloqueos económicos, «que solo asfixian a los pueblos en medio de esta crisis humanitaria».
Por otro lado, como es habitual en los discursos ante la ONU de los presidentes argentinos, Fernández reafirmó los «legítimos e imprescriptibles derechos de soberanía» de su país sobre las Islas Malvinas y los espacios marítimos circundantes, que dijo «se encuentran ocupados ilegalmente por el Reino Unido desde hace ya más de 187 años».
«El Reino Unido persiste en su actitud de desoír el llamado a reanudar las negociaciones respecto de la disputa territorial y ha agravado la controversia por los llamados a la explotación ilegal y unilateral de los recursos naturales renovables y no renovables en el área», reprochó Fernández, que criticó la «desmedida presencia militar» inglesa en las islas.
Asimismo, sacó a colación la impunidad que aún persiste en torno al atentado terrorista contra la mutual judía AMIA de Buenos Aires, que dejó 85 muertos en 1994 y que la Justicia argentina atribuye a Irán y al grupo Hizbulá.
Por ello, requirió a las actuales autoridades persas que cooperen con las autoridades judiciales argentinas para avanzar en la investigación del ataque. EFE